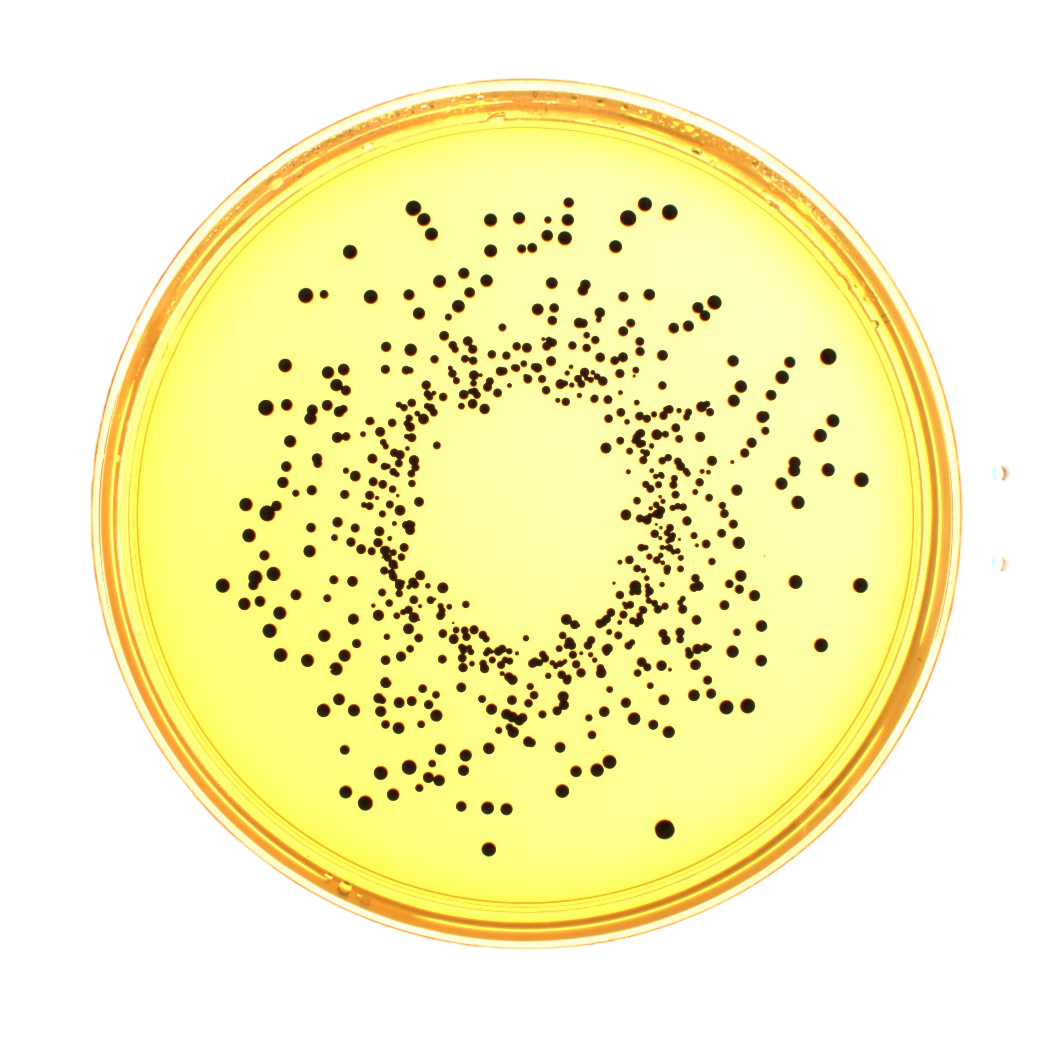
WASP TOUCH螺旋接种仪
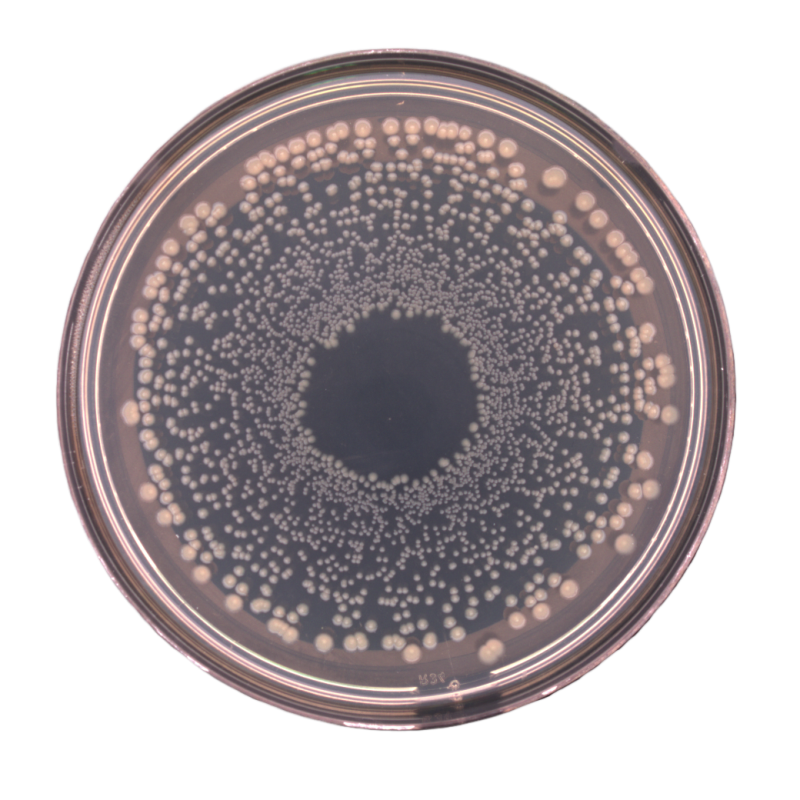
WASP TOUCH螺旋接种仪

产品线
PRODUCTS
WASP TOUCH螺旋接种仪
WASP TOUCH螺旋接种仪,触摸屏操作,⽤⼾界⾯友好,⾃动化程度⾼,可⼴泛应⽤于⻝品、医药、化妆品、⽔、临床及微⽣物研究等领域对微⽣物含量较⾼的样品的定量检测、抑菌测试和挑战实验等,尤其适⽤于培养基⽣产企业及制药⾏业的微⽣物培养基适⽤性研究和质控。
产品详情
Product Details
-
产品概要
-
产品参数
产品特点
-
01节约成本与倾注平板法相⽐,螺旋接种法对于菌数多⾄4.0×105cfu/mL的样品,只需⼀块90mm琼脂平板即可,⽆需梯度稀释,⽆需倒4~6块平板,解决平时菌落总数检测时不知取哪个稀释度倒平板的问题,节省80%的费⽤,节省90%时间。
-
02定量接种培养基⽣产企业和制药企业需要经常做培养基质控和培养基适⽤性检测,对定量接种要求很⾼,与传统涂布平板法相⽐,螺旋接种⽅法的优势1)螺旋接种仪的接种头采⽤特富⻰不沾材料,⽆需担⼼传统涂布⽅法中涂布棒沾菌液的问题;2)⽆需担⼼涂布平板边缘菌落聚集成团导致⽆法计数的问题;
-
03抑菌实验和挑战实验在进⾏消毒剂和防腐剂抑菌实验和挑战实验中,需要添加⾼达106的菌液,每隔 ⼀段时间需要取样品进⾏计数,⽤螺旋接种仪特别⽅便,⽆需梯度稀释,直接取样中和后划平板即可。
产品参数
-
触摸屏
4.3英⼨彩⾊液晶触摸屏控制,智能友好;
-
接种针
不粘样品的特富⻰材料接种针,⽆需⼀次性接种头;
-
接种模式
标配50uL和100uL两种容量的对数螺旋接种模式(log模式);
-
模式扩充
可选1000ul⼤容量注射器功能扩充模块,增加10uL和200uL对数接种模式(LOG模式),增加50、100、200、500、1000uL线性均匀接种模式(lin模式);
-
平皿尺寸
标配90mm平⽫,尺⼨在⼀定范围内⾃动调整;可选配55mm或150mm接种平台;
-
数据管理
可选配数据处理和记录模块,可记录⽇期、时间、⽤⼾名、平板编号、体积、接种模式、校正⽇期及校正体积、上次操作的开始时间、完成位置检测的时间以及上次执⾏染料接种的时间;可进⾏不同⽤⼾等级的密码保护;可通过U盘下载数据,然后由Excel进⾏数据处理;⽹络接⼝提供数据传输及远程诊断服务;
-
LIMS系统
支持,可接条码仪;
-
电⼒要求
110-240V,50Hz;
-
主机重量
21.5Kg。